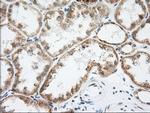
LOX Antibody in Immunohistochemistry (Paraffin) (IHC (P))

Search
OriGene
LOX Monoclonal Antibody (OTI4E3), TrueMAB™
{{$productOrderCtrl.translations['antibody.pdp.commerceCard.promotion.promotions']}}
{{$productOrderCtrl.translations['antibody.pdp.commerceCard.promotion.viewpromo']}}
{{$productOrderCtrl.translations['antibody.pdp.commerceCard.promotion.promocode']}}: {{promo.promoCode}} {{promo.promoTitle}} {{promo.promoDescription}}. {{$productOrderCtrl.translations['antibody.pdp.commerceCard.promotion.learnmore']}}
产品信息
CF500865
种属反应
宿主/亚型
分类
类型
克隆号
抗原
偶联物
形式
浓度
纯化类型
保存液
内含物
保存条件
运输条件
产品详细信息
For reconstitution, we recommend adding 100 µL distilled water to a final antibody concentration of about 1 mg/mL. To use this carrier-free antibody for conjugation experiments, we strongly recommend performing another round of desalting. (Zeba Spin Desalting Columns, 7KMWCO, 0.5 mL, Product # 89882)
靶标信息
Lysyl oxidase (LOX), a copper-containing amine oxidase, belongs to a heterogeneous family of enzymes that oxidize primary amine substrates to reactive aldehydes. It plays a vital role in the formation and repair of the extra cellular matrix. As well, LOX is a multifunctional enzyme having diverse biological functions such as developmental regulation, tumor suppression, cell motility and cellular senescence. The secreted form of LOX is responsible for the invasive properties of hypoxic human cancer cells. Thus, it is essential for hypoxia-induced metastasis and is a good therapeutic target for preventing and treating metastases.
仅用于科研。不用于诊断过程。未经明确授权不得转售。
篇参考文献 (0)
生物信息学
蛋白别名: Lysyl oxidase; MGC105112; Protein-lysine 6-oxidase
基因别名: LOX
UniProt ID: (Human) P28300
Entrez Gene ID: (Human) 4015